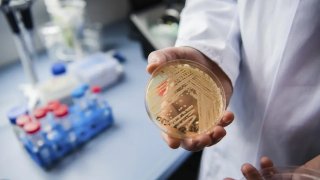
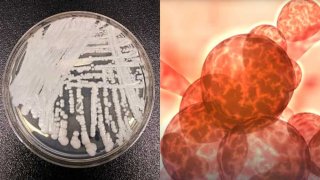

เชื้อรา


ชายจีนลืมชามข้าวไว้ที่ออฟฟิศเกือบเดือน ก่อนกลับมาเจอก้อนผมสุดแปลกในชาม
"หยิน" ซึ่งมีภูมิลำเนาอยู่ที่เหอเฟย มณฑลอันฮุย ประเทศจีน และ ปัจจุบันประกอบธุรกิจเฟอร์นิเจอร์ไม้ในเมืองหนิงโป มณฑลเจ้อเจียง ได้เผลอลืมชามข้าวหน้าเนื้อไว้ในสำนักงานก่อนเดินทางกลับบ้านในช่วงตรุษจีน เมื่อวันที่ 10 กุมภาพันธ์ 2026 เขาเก็บสัมภาระกลับบ้านเพื่อฉลองปีใหม่ด้วยความเร่งรีบ ทำให้ชามข้าวหน้าเนื้อที่เหลือ ซึ่งตั้งใจจะเก็บไว้ให้สุนัขกิน ไม่ได้ถูกจัดการและถูกทิ้งไว้ในห้องทำงานที่ปิดสนิท จนกระทั่.. ดูเพิ่ม

เด็กหญิงป่วยติดเชื้อราจนสมองถูกทำลาย หลังทำความสะอาดบ้านเก่า
เหตุการณ์ทำความสะอาดบ้าน ที่ดูเหมือนไม่มีอันตราย กลับเกือบกลายเป็นโศกนาฏกรรม โดยเหตุการณ์ดังกล่าว เกิดขึ้นที่เมืองเจิ้งโจว มณฑลเหอหนาน ประเทศจีน โดยเด็กหญิงวัย 6 ขวบมีไข้สูงติดต่อกันนานถึง 17 วัน หลังจากเข้ารับการรักษาในโรงพยาบาล ผลการตรวจทำให้แพทย์รู้สึกตกตะลึงอย่างยิ่ง เมื่อพบว่าสมองของเด็กถูก "เชื้อรา" รุกรานอย่างรุนแรง ส่งผลทำให้เกิดโพรงมากกว่า 20 จุด ที่มีขนาดแตกต่างกัน ซึ่งเป็นอันตรายต่อชีว.. ดูเพิ่ม

เคล็ดลับใช้ยาดมให้ปลอดภัย ไม่ระคายจมูก ไม่เสี่ยงเชื้อรา! เตือนใช้มากไปอาจทำให้ “โพรงจมูกอักเสบ”
ยาดมคือไอเท็มยอดนิยมที่ชาวไทยและต่างชาติชื่นชอบ เมื่อสูดดมจะทำให้โล่งจมูกและสดชื่นทันที แต่ แด๊ดดี้จอแดน ขอเตือนว่า! การใช้ยาดมไม่ถูกวิธี ใช้มากเกินไป หรือเก็บรักษาผิด อาจก่อให้เกิดอันตรายได้เช่นกัน โดยเฉพาะการสูดดมที่เป็นนิสัยในปริมาณมาก อาจนำไปสู่ โพรงจมูกอักเสบ ได้! มาดูวิธีใช้ยาดมให้ปลอดภัยที่สุดกันยาดมที่วางจำหน่ายส่วนใหญ่ประกอบด้วย สารหลักสำคัญ เช่น เกร็ดสะระแหน่, การบูร, พิมเสน รวมถึงน้ำมั.. ดูเพิ่ม

“เชื้อรามรณะ” บุกอเมริกา – แผนโจมตีแหล่งอาหารของชาติ?
“เชื้อรามรณะ” บุกอเมริกา – แผนโจมตีแหล่งอาหารของชาติ? Fungal Outbreak Apocalypse Day? หรือวันสิ้นโลกของฟาร์มอาหารอเมริกันกำลังจะมาถึง! สหรัฐฯ สะเทือน! เอฟบีไอจับกุม 2 ชาวจีนที่ลักลอบขน “เชื้อรามรณะจากห้องแล็บ” เข้าอเมริกา – สิ่งที่พวกเขานำเข้ามาไม่ใช่อาวุธนิวเคลียร์ แต่เป็น “Fusarium graminearum” เชื้อราที่อาจเปลี่ยนไร่ข้าวโพดให้กลายเป็นป่าผีร้าง! ห.. ดูเพิ่ม

ดูแลหนังศีรษะไม่ดี รังแคขึ้น ไม่น่าดู เสียบุคลิก!
บางคนแต่งหน้าดี แต่งตัวเป๊ะ พูดจาน่าฟัง แต่พอขยับผมออกนิดเดียว...ขาวโพลนเต็มไหล่ “รังแค” เป็นปัญหาเล็ก ๆ ที่ใคร ๆ ก็ไม่อยากเจอ เพราะแม้จะไม่อันตราย แต่กลับกระทบความมั่นใจและบุคลิกภาพไม่น้อย และปัญหานี้มักเริ่มต้นจากสิ่งที่มองข้าม — การดูแลหนังศีรษะ รังแคคืออะไร เกิดจากอะไรแน่? รังแคคือเซลล์ผิวหนังที่ตายแล้วและหลุดลอกออกมามากผิดปกติ ในคนทั่วไป เซลล์ผิวหนังของศีรษะจะผลัดตัวทุก 28 .. ดูเพิ่ม

เชื้อราร้ายใกล้ตัวรู้เท่าทัน 6 เชื้อราที่พบได้ง่าย แต่สามารถคร่าชีวิตคนได้
ในสายตาหลายคน "เชื้อรา" อาจฟังดูไม่อันตรายเท่าไวรัสหรือแบคทีเรีย แต่ในความจริงแล้ว เชื้อราบางชนิดสามารถ ลุกลามเข้าสู่กระแสเลือด ปอด สมอง และหากไม่ได้รับการรักษาอย่างทันท่วงที... มันสามารถคร่าชีวิตคนได้ ที่สำคัญคือ เชื้อราหลายชนิดพบได้ในสิ่งแวดล้อ มทั่วไปรอบตัวเรา เช่น ดิน ใบไม้ ฝุ่นในบ้าน หรือแม้แต่ในร่างกายของเราเอง เรามาทำความรู้จักกับ 6 เชื้อราร้ายเหล่านี้ ที่คุณอาจพบเจอทุกวันโดยไม่รู้ตัว 1. A.. ดูเพิ่ม
CDC เตือน "เชื้อราดื้อยาร้ายแรง ได้แพร่กระจายแล้ว"
เชื้อราซูเปอร์บักที่เรียกว่า "แคนดิดา ออริส" กำลังแพร่กระจายในโรงพยาบาล และ สถานดูแลผู้สูงอายุด้วยอัตราที่น่าตกใจ โดยศูนย์ควบคุมและป้องกันโรคของอเมริกา เรียกเชื้อนี้ว่า "ภัยคุกคามต่อการดื้อยาต้านจุลชีพ" หลังจากที่มันได้แพร่กระจายไปทั่วแล้ว... วันนี้ [ตามเวลาท้องถิ่น] ศูนย์ควบคุมและป้องกันโรคของอเมริกา ได้ออกมากล่าวเตือน เกี่ยวกับภัยคุกคามที่เพิ่มมากขึ้นของเชื้อ "แคนดิดา ออริส" เนื่องจากเชื้อนี้ไม.. ดูเพิ่ม

Mycology: การศึกษาเชื้อราและบทบาทที่สำคัญในชีวิตประจำวัน
ผู้เขียน: Boss Panuwat Mycology คืออะไร? Mycology (ไมคอลอจี) คือสาขาหนึ่งของชีววิทยาที่ศึกษาเกี่ยวกับเชื้อรา รวมถึงลักษณะทางพันธุกรรมและชีวเคมี, การจำแนกประเภท, และการใช้ประโยชน์จากเชื้อราในหลายๆ ด้าน ไม่ว่าจะเป็นการนำมาใช้เป็นวัสดุในการจุดไฟ, ยารักษาโรค, อาหาร, และสารเสพติดสำหรับวิญญาณ รวมไปถึงอันตรายจากเชื้อรา เช่น ความเป็นพิษหรือการติดเชื้อที่อาจเกิดขึ้น นักวิทยาศาสตร์ที่เชี่ยวชาญด้านการศึกษาเ.. ดูเพิ่ม

เชื้อราอันตรายแพร่กระจายในเทศกาลดนตรีของแคลิฟอร์เนีย
เจ้าหน้าที่สาธารณสุขของรัฐแคลิฟอร์เนีย ได้ออกมากล่าวเตือนว่า "ผู้เข้าร่วมเทศกาลดนตรีกลางแจ้งยอดนิยมหลายพันคน [เทศกาลสายฟ้าในขวด ซึ่งจัดขึ้นที่ทะเลสาบบูเอนาวิสตา รัฐแคลิฟอร์เนีย ประเทศอเมริกา ตั้งแต่วันที่ 21-25 พฤษภาคม 2024] ซึ่งอาจสัมผัสกับเชื้อราที่เป็นอันตราย และ อาจถึงแก่ชีวิตได้..." และ "เชื้อราดังกล่าว จะทำให้ผู้ติดเชื้อ กลายเป็นไข้วัลเลย์" งานดังกล่าว จัดห่างจากลอสแอนเจลิส ไปทางตะวันตกเฉีย.. ดูเพิ่ม

สาวช็อก!! หลังจอดรถหรู ไว้ชั้นใต้ดินครึ่งเดือน
ภาพที่กำลังเป็นไวรัลในจีนตอนนี้ คือ ภาพที่ชาวเน็ตหญิงคนหนึ่ง ได้จอดรถปอร์เช่ของเธอไว้ในลานจอดรถชั้นใต้ดิน ในเมืองเซี่ยงไฮ้ ประเทศจีน ในช่วงหน้าฝน เนื่องจากต้องกลับบ้านเกิดกระทันหัน ปรากฏว่าหลังจากวันเวลาผ่านไปครึ่งเดือน เธอก็เปิดประตูเพื่อเช็กดูก็พบว่า ภายในรถเต็มไปด้วยเชื้อราทั้งหมด... ชาวเน็ตหญิง ระบุว่า "มันเป็นอะไรที่ไม่เคยคาดคิด เลยว่ามันจะเกิดอะไรแบบนี้ขึ้น" และ "ฉันจะขับรถไปที่ศูนย์ล้างรถ .. ดูเพิ่ม

ชาวเน็ตพบเห็ดงอกในบ้าน หลังฝนตกติดกัน 59 วัน
เกิดฝนตกหนักต่อเนื่อง ทางตอนใต้ของประเทศจีน โดยเฉพาะในกวางโจว ซึ่งเป็นเวลากว่า 59 วันแล้ว ที่ฝนตกติดต่อกัน มีเพียง 7 วันเท่านั้นที่ฝนไม่ตก ซึ่งทุกสิ่งที่อยู่นอกบ้าน ถูกเปลี่ยนแปลงไปหมด เช่น บ้านเรือนมีเชื้อรา มีน้ำท่วมหรือน้ำขัง และ บ้านของชาวเน็ตคนหนึ่ง มีเห็ดงอกมาจาก รอยแตกร้าวของกำแพง... แพทย์ได้ออกมาเตือนว่า "บริเวณที่มีเชื้อรา อาจทำให้เกิดอาการไอ และ หายใจลำบากได้ง่าย โดยเฉพาะในผู้สูงอายุ แล.. ดูเพิ่ม

สภาพของตั๊กแตน ที่โดนเชื้อรากัดกินจนกลายเป็นตั๊กแตนซอมบี้เด้อครับเด้อ น่ากลัวดีเหมือนกันนะเนี่ย
ภาพที่เราได้เห็นอยู่นี้เป็นสภาพของตั๊กแตน ชนิด Carolina leaf-roller grasshopper ก่อนและหลังเจอเชื้อราคอร์ดิเซปกัดกินเข้าไปในร่างกายจนกลายเป็นซอมบี้ เชื้อราจะบังคับให้ตั๊กแตนปีนขึ้นไปบนต้นไม้สูง ทั้งๆที่โดยปกติแล้วพวกมันจะอาศัยอยู่บนพื้นดิน จากนั้นเชื้อราก็จะระเบิดออก เพื่อแพร่กระจายเชื้อสปอร์ของเชื้อราชนิดนี้ให้ปลิวไปตามลมเป็นระยะทางหลายกิโลเมตรเลยทีเดียว และก็จะมีตั๊กแตน หรือแมลงโชคร้ายตัวอื่นๆ .. ดูเพิ่ม

อยู่บ้านใหม่ 2 เดือน น้ำหนักพุ่ง 10 กก. ป่วยหนัก???
คุณเอมี่ สคิลตัน หญิงสาวชาวออสเตรเลีย ย้ายไปอยู่บ้านใหม่ในปี 2559 หลังจากย้ายไปอยู่ได้เพียง 2 เดือน เธอก็เริ่มมีอาการผิดปกติ เช่น ภูมิแพ้ น้ำหนักขึ้น เหนื่อยล้า ไม่มีสมาธิ ทำงานลำบาก สูญเสียความทรงจำ บางครั้งถึงขั้นจำชื่อตัวเองไม่ได้ เธอไปตรวจสุขภาพหลายครั้ง แต่ผลออกมาปกติ กระทั่งปี 2560 เธอบังเอิญอ่านโพสต์ของเพื่อนในโซเชียลฯ เกี่ยวกับอาการป่วยที่เกิดจากเชื้อรา เธอจึงขอให้ผู้เชี่ยวชาญตรวจบ้านและพ.. ดูเพิ่ม
พามาด้วย
พามาด้วย หลายครั้งที่หมอต้องบอกให้ญาติผู้ป่วยที่มาขอรับยาแทน พาคนไข้มาด้วย เพื่อมาตรวจบ้าง(ถ้าคนไข้สะดวก) ไม่ใช่จ่ายยาเดิมอย่างเดียว อาจจะปีละครั้งก็ยังดี แต่เคสนี้แปลกครับ เด็กชายวัย11ปี มากับพ่อและน้าชาย บอกว่ามีสีผิวที่นิ้วเท้าผิดปกติ ผมก็ไปตรวจดู ผิดปกติจริง ตรงข้อหลังนิ้วเท้าชี้ กลาง นาง ก้อย ทั้งสี่นิ้ว มีวงๆขาวๆ น้องมีอาการคันบ้าง "นี่ สงสัยเพราะไปใส่รองเท้า น้ามันแน่เลย" พ่อของเด็ก ชี้ไปที.. ดูเพิ่ม

ชายอินเดีย ติดเชื้อราจากพืชพบฝี ในหลอดลม
สื่อนอกรายงานว่า "พบผู้ติดเชื้อราจากพืช คนแรกของโลก ที่เมืองโกลกาตา ประเทศอินเดีย ซึ่งผู้ป่วยเป็นผู้เชี่ยวชาญด้านเห็ดและเชื้อรา วัย 61 ปี ซึ่งเขาต้องทนทุกข์ทรมานจากอาการไอเรื้อรัง เสียงแหบ กลืนลำบาก เจ็บคอ และ อ่อนเพลีย ตลอดระยะเวลา 3 เดือนหลังติดเชื้อ..." และ "เขาได้ทำงานคลุกคลีอยู่กับวัตถุที่เน่าเปื่อย เห็ดชนิดต่างๆ และราจากพืชหลากหลายชนิด มาเป็นระยะเวลานาน ซึ่งเป็นส่วนหนึ่งของงานด้านการวิจัยขอ.. ดูเพิ่ม
เชื้อรามฤตยู แพร่กระจายทั่วอเมริกาแล้ว!!
สื่อนอกรายงานว่า "เกิดการติดเชื้อราที่ลึกลับ และ เป็นอันตรายถึงชีวิตที่เรียกว่า "Candida Auris" ซึ่งกำลังแพร่กระจายไปทั่วอเมริกาอย่างรวดเร็ว โดยศูนย์ควบคุมและป้องกันโรคของอเมริกา ได้ออกมาแจ้งเตือนถึงการติดตามเชื้อราดังกล่าว โดยเชื้อดังกล่าวเป็นหนึ่งใน 19 เชื้อก่อโรค ที่มีความสำคัญต่อเชื้อรา!!" และ "เชื้อราที่ดื้อยาหลายตัว ถูกค้นพบครั้งแรกในญี่ปุ่นเมื่อ 15 ปีก่อน มีผู้ติดเชื้อมากถึง 2,377 คนในอเมร.. ดูเพิ่ม
หนึ่งคนสามเชื้อ
คุณป้าคนนึง วัย62ปี มาด้วยอาการผื่นคัน ที่ข้อเท้า แต่ประวัติเก่า เคยเป็นแผล ฝี ที่ก้น แล้วมาทำแผลหลายวัน เรื่องผื่นคัน ที่ข้อเท้า ช่วงนี้ฝุ่นpm2.5 เยอะ บางคนไม่ได้มีน้ำมูกไอจาม แต่มีผื่นคัน คล้ายภูมิแพ้ง่าย คนที่จะเกิดอาการ ต้องภูมิคุ้มกันไม่ค่อยดี เช่น นอนดึก เครียด ทานของทอดเยอะ ไม่ค่อยออกกำลังกาย หมอกอล์ฟสอบถามคุณป้าไป พบว่ามีทานของทอดบ้าง น้ำเย็นบ้าง นอนดึกบ้าง แต่ที่แน่ๆ คุณป้าบอกว่าคันมาก ก็.. ดูเพิ่ม

ซอมบี้ในชีวิตจริง!!! เชื้อราในชีวิตจริงที่เป็นแรงบันดาลใจให้กับผู้ติดเชื้อใน 'The Last of Us'
"The Last of Us" เป็นซีรีย์ที่กำลังมาแรงอ้างอิงจากเกมในชื่อเดียวกันว่าด้วยโลกหลังหายนะซึ่งมนุษยชาติถูกทำลายด้วยการติดเชื้อราที่อันตรายถึงชีวิต รวมถึงมนุษย์ที่ติดเชื้อราที่ออกมาล่าผู้ที่ยังรอดชีวิต เนื้อเรื่องสุดระทึกขวัญนี้ทำให้เกิดข้อสงสัยว่า เหตุการณ์เช่นนี้จะเกิดขึ้นในชีวิตจริงได้หรือไม่? และถ้ามีจริงธรรมชาติจะสร้างเชื้อมาในรูปแบบใด เชื้อราสุดอันตรายฝันร้ายที่มีอยู่จริง Cordyceps และ Ophiocord.. ดูเพิ่ม
